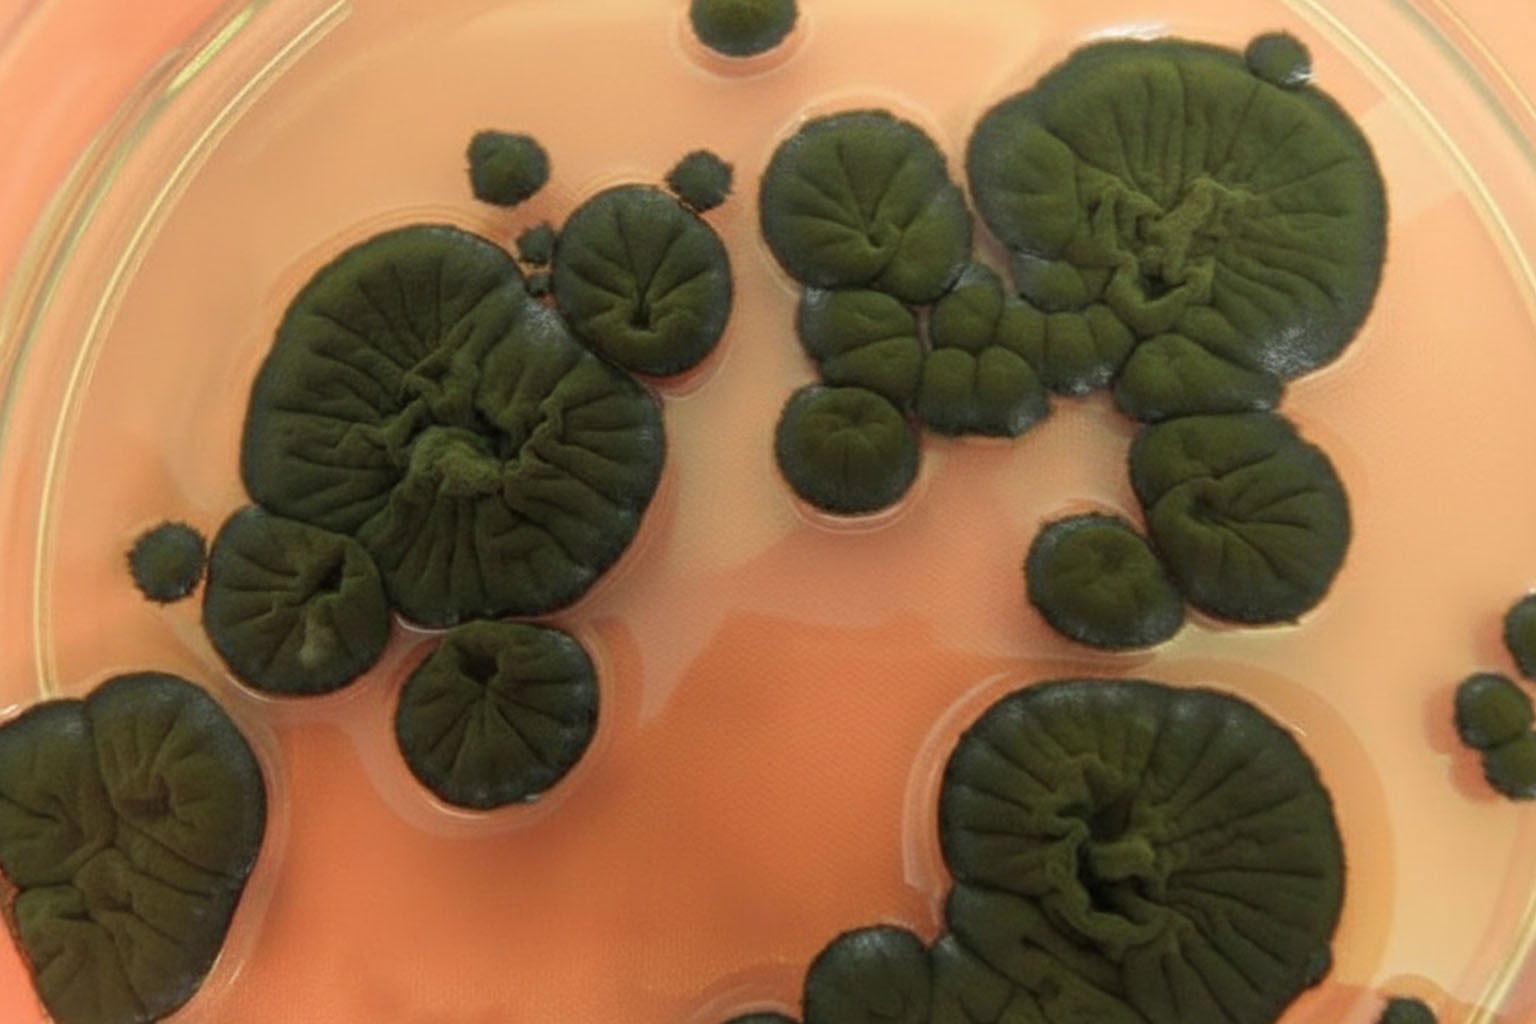

Have you ever stumbled upon a story so unbelievable that it shakes how you view life as we know it? That’s precisely the tale behind a peculiar black fungus thriving in the Chernobyl Exclusion Zone, right where many might think life would be impossib…